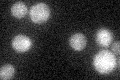
YBR249C
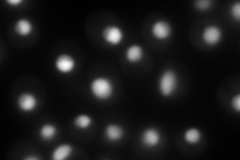
YBR249C
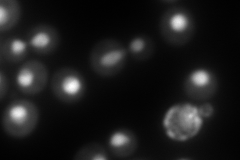
YBR249C

View description
3-deoxy-D-arabino-heptulosonate-7-phosphate (DAHP) synthase, catalyzes the first step in aromatic amino acid biosynthesis and is feedback-inhibited by tyrosine or high concentrations of phenylalanine or tryptophan
Localization:
Intensity:
Fold change:
Significance:
-
C’ GFP library in SD
below threshold18.39 -
N' NOP1pr-GFP in SD
nucleus385.444 -
N' TEF2pr-mCherry in SD
nucleus386.62 -
N' NATIVEpr-GFP in SD

nucleus284.159 -
N' TEF2pr-VC and Cyto-VN in SD

#N/A0 -
C’ GFP library in SD+DTT

cytosol14.420.78No -
C’ GFP library in SD+H2O2

cytosol16.930.92No -
C’ GFP library in Starvation Media

cytosol28.431.54No -
C’ GFP library on the background of Pup2-DaMP

below threshold -
C’ GFP library on the background of CCT mutant

below threshold16.73130.909386No
